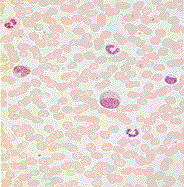

|
Anfärbung und Beurteilung der Blutzellen im Ausstrichpräperat wird seit Paul Ehrlich weltweit genutzt, Färbebank Hämatologisches Laboratorium
|
|
|
|
|
|
Universitäts Krankenhaus Eppendorf, Hamburg
|
Krankenhaus Korma, Weißrussland
|
Notfall - Ambulanz, Tschernobyl Region
|
|
als einfache, Klima und Wartung unabhängige kostengünstige diagnostische Methode in der ärztlichen Versorgung.

Arbeitsplatz mit Mikroskop und Färbebank ( Kosten je nach Mikroskop ab 5000 EUR )
Statistische Auswertung physikalisch chemischer Automatenanalyse kann die kreative Freude und biologische Information der mikroskopischen Beurteilung des Blutausstriches nicht ersetzen. Die mikroskopisch beurteilten Blutzellen sind Fenster,

die über unspezifische
Bakterielle Infektion Sepsis
und spezifische
 
Virusinfektion Mononukleosis Infectiosa
Abwehrreaktionen informieren, auf Störungen der Erytrozytenbildung und Hb-Synthese hinweisen,
|
|
|
|
|
Thalasämie
|
Eisenmangel
|
Sichelzellanemie
|
Blutparasiten nachweisen, allergische Reaktionen
 
Malaria Eosinophilie
und reaktive Veränderungen der Knochenmarkfunktion anzeigen,
 
Polychromasie
atypische Blutzellen erkennen akute Lymphatische Leukemie Monozytenleukemie
und die Abschätzung von Leukozytenzahl und Thrombozytenzahl ermöglicht. Erleuterung in " das Schnelldifferentialblutbild " ( 6 ) Die visuelle Wahrnehmung ( 7 ) und Erinnerung im visuellen Context ( 8) bei der diagnostischen Einordnung der Blutzellen im Ausstrichpräparat ist in vielen Schritten ein immer noch ungeklärtes Wunder, das mit den unbekannten Dimensionen des Weltalls vor 15 Millarden Jahren begonnen hat ( 9 ). Maxwell hatte erkannt, daß das Licht eine elektromagnetische Welle ist ( 10 ), welche die wichtige Eigenschaft hat, mit den chemischen Stoffen unsere Netzhaut zu reagieren und so die Sinnesmodalität des Sehens ermöglicht. Voraussetzung war ein 3 Millarden Jahre dauernder evolutionärer Proßeß ( 11 )auf unserer Erde vom lichtempfindlichen Einzeller ( 12 ), der seine biochemischen Möglichkeiten nutzen konnte, Sonnenlicht zur Energiegewinnung einzufangen , bis zum menschlichen Auge ( 13 ) und den neuralen Vernetzungen der visuellen Wahrnemung ( 14 ). Das Internet-file " Blutbild und Urinstatus " erklärt in einfacher Weise die Herstellung des Blutausstriches

und weist auf die über 100 Jahre alten, nach wie vor aktuellen diagnostischen Möglichkeiten, des Differential-Blutbildes ( 2, 3, 4 ) hin diese Hinweise sollten erkannt und wenn nötig ergänzt werden mit Hilfe moderner Untersuchungstechniken in Speziallaboratorien ( 15 )
|